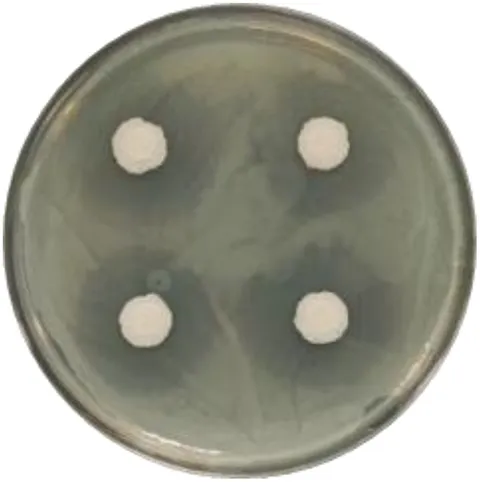
Frontiers | Isolation and identification of a novel Bacillus

マイストア
変更
お店で受け取る
(送料無料)
配送する
納期目安:
2026.02.20 12:12頃のお届け予定です。
決済方法が、クレジット、代金引換の場合に限ります。その他の決済方法の場合はこちらをご確認ください。
※土・日・祝日の注文の場合や在庫状況によって、商品のお届けにお時間をいただく場合がございます。
willinckii Bacteria×Ferret② The only few dwarf platy we grow, slow but fun! P. willinckiiの詳細情報
The only few dwarf platy we grow, slow but fun! P. willinckii。農業生物資源ジーンバンク - 微生物遺伝資源の詳細 - MAFF 306347。BIFIDOBACTERIUM - Williams Cancer Institute。willinckii Bacteria×Ferretスーパードワーフとドワーフサイズのmix同じ親から生まれても、☑︎形☑︎毛の出方☑︎葉性☑︎将来性すべてが違う、一点もの。Functional Profiling of Kiwifruit Phyllosphere Bacteria: Copper。今はまだ小さくても、数年後には「化ける」可能性を秘めています。たーくん出品。それこそが胞子培養の最大の魅力であり、ロマン。ビカクシダ P.Willinckii Tiara spore 01。・将来どんな姿になるのか・唯一無二の個体になるのか育てる楽しみは、株と一緒に大きくなっていきます。限定1株 P. willinckii 'Cold moon’ OC ウィリンキー。完成品を買うのではなく、未来を育てたい方へ。ビカクシダ☆yellow moon dwarf spore☆selected株。胞子培養ならではのワクワクを、ぜひ体感してください
ベストセラーランキングです
近くの売り場の商品
カスタマーレビュー
オススメ度 4.4点
現在、4884件のレビューが投稿されています。